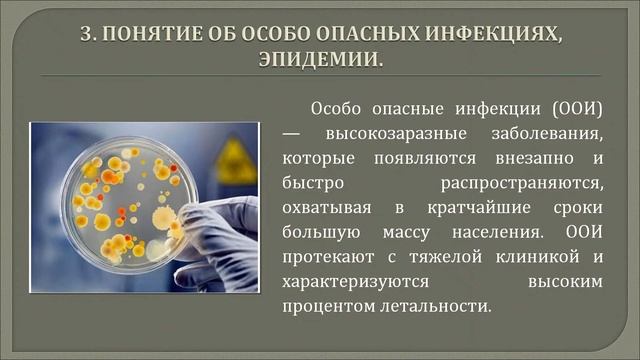
Основы эпидемиологии смотреть онлайн

Автор: InkedAdventuresPodcast Страница 4

Токийский гуль | Шедевр или Пустая трата времени? | Стоит ли смотреть? | Обзориус #1

Сильнейшие цитаты Льва Толстого заставят тебя пересмотреть всю свою жизнь | Цитаты великих людей

Женская тюрьма

Станислав Дробышевский. Динозавры 2.0: ответы на вопросы

Сакральная геометрия в татуировке

Цифровая функция #4. Лев Соломадин. Цифровизация холдинга СИБУР

Как связать рождественский венок крючком

Кровь после соды

Триумфальное возвращение Юли Волковой Вайфайтери

ДК СМОТРИТ : МНЕ УГРОЖАЛИ! (Обращение к NIKITA EFREMOV, Аудитории, Пабликам)

7 Смертных Грехов. "Дочь" Эсканора и Мерлин. Глаз демона у Тристана. Просто Перси

Моё прохождение за Паладина в Baldur's Gate 3 ☀️
Основы эпидемиологии

день вдв 2011року луцьк

Tattoo in Kabul

Сергей Балык Бокал вина

опенинг Токийского Гуля

DUOSKIN- КАК ТАТУИРОВКУ-ТАЧПАД МОЖНО РАСПОЛОЖИТЬ НА ЛЮБОМ МЕСТЕ ВАШЕГО ТЕЛА-NEXTIDEA

НАША САМАЯ ДОРОГАЯ ПОКУПКА НА ALIEXPRESS!

НОМЕР ЗА $50 000 В ОТЕЛЕ АТЛАНТИС, ДУБАЙ (Dubai. Atlantis. The Palm Jumeirah)

Эти звездные девушки Знак зодиака Гороскоп Близнецы вы их не провоцируете кыз кыздар қыз

Forearm Tattoo half done 2nd Sitting after 1 month remaining #shorts #tattooartist #trending #art

Enfants de gitans : Une vie de roi

Загар, рак кожи и SPF
За каждым успешным каналом стоит личность, идея и сотни часов кропотливого труда. Если вы здесь, значит, автор «InkedAdventuresPodcast» уже сумел зацепить ваше внимание своим уникальным стилем или подачей. А мы на RUVIDEO позаботились о том, чтобы вы могли изучить весь архив его работ в максимально комфортных условиях — без лишней суеты и преград.
Почему за работами канала «InkedAdventuresPodcast» так интересно наблюдать? Всё просто: это честный контент, который находит отклик в сердцах зрителей. На нашем ресурсе вы можете смотреть онлайн все видео любимого автора бесплатно и в хорошем качестве. Нам важно, чтобы вы видели каждую деталь и слышали каждый нюанс, поэтому мы используем только стабильные плееры из открытых источников Rutube.
Следите за новинками канала, пересматривайте старые шедевры и открывайте для себя новые грани творчества «InkedAdventuresPodcast». Мы постоянно обновляем ленту, чтобы у вас под рукой всегда были самые свежие выпуски. Никаких сложных регистраций — только вы и творчество, которое вдохновляет. Приятного вам путешествия по миру авторского контента на RUVIDEO!
Видео взято из открытых источников Rutube. Если вы правообладатель, обратитесь к первоисточнику.